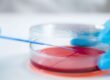

In the dynamic arena of biotechnology, the cultivation and harnessing of bacteria stand at the forefront of pushing the boundaries in research, pharmaceutical development, and industrial enhancements. Amidst the array of technologies propelling the efficiency and effectiveness of bacterial production, high-pressure homogenizers have become a beacon for breakthroughs, with Hommak Homogenizers leading the charge. This blog post explores the critical importance of high-pressure homogenizers in bacterial production for the biotech sector, spotlighting the exceptional benefits that Hommak Homogenizers bring to the table.
Bacterial Production: A Biotech Pillar
Bacterial production is the bedrock of biotechnology, playing a pivotal role in generating a vast spectrum of products, from lifesaving antibiotics and vaccines to vital enzymes and sustainable biofuels. Bacteria, with their simplistic genetic structures and rapid proliferation capabilities, are prime candidates for genetic modification, paving the way for the mass production of crucial substances. The capacity to tailor bacterial strains for specific protein or metabolite outputs has heralded new frontiers in medicine, agriculture, and environmental conservation.


High-Pressure Homogenizers: The Backbone of Bacterial Production
At the heart of bacterial production lies the indispensable process facilitated by high-pressure homogenizers – breaking down bacterial cell walls to liberate intracellular products or to prime cells for subsequent processing. This critical step, known as cell disruption or lysis, is essential for extracting valuable biochemicals from bacteria. High-pressure homogenization not only guarantees effective cell breakdown but also ensures the consistency and dependability of the end product. The advancement in high-pressure homogenization technology has been tailored to high-volume, scalable production needs, emphasizing minimal heat generation, contamination prevention, and standardized cell disruption.
Hommak Homogenizers: Leading with Advantages
Hommak Homogenizers distinguish themselves with pioneering features and bespoke solutions tailored for the biotech industry. Below are pivotal advantages that position Hommak Homogenizers as the go-to choice for bacterial production professionals:
Efficiency and Uniformity: Engineered for high-performance cell disruption, Hommak Homogenizers achieve unparalleled efficiency and uniformity in the homogenization process, crucial for maintaining the end product’s quality consistency.
Scalability: Hommak Homogenizers offer a versatile range of models to support various volumes and throughput demands, from research labs to large-scale industrial setups, facilitating seamless lab-to-market transitions.
Controlled Heat Generation: Addressing the challenge of heat production, crucial in preserving protein integrity, Hommak Homogenizers are designed to keep heat generation at a minimum, safeguarding sensitive biological materials.
Ease of Sterilization and Cleaning: Featuring design innovations that streamline sterilization and cleaning, Hommak Homogenizers reduce downtime and uphold strict biotechnological production hygiene standards.
Customization and Support: Hommak’s commitment to providing customized solutions and extensive technical support ensures optimized homogenization processes and superior outcomes, reflecting a customer-first approach.
Conclusion
High-pressure homogenizers, particularly those from Hommak, are indispensable in the biotechnology sector’s bacterial production processes. Their efficiency in cell disruption, coupled with scalability, reduced heat generation, ease of cleaning, and comprehensive support services, render them essential for both researchers and the industry. As biotechnology strides forward, the contributions of high-pressure homogenizers to fostering innovations and enhancing production processes will undeniably continue to be critical. Hommak’s dedication to innovation and excellence cements its leadership in the field, offering advanced solutions that meet the growing demands of biotechnological applications.